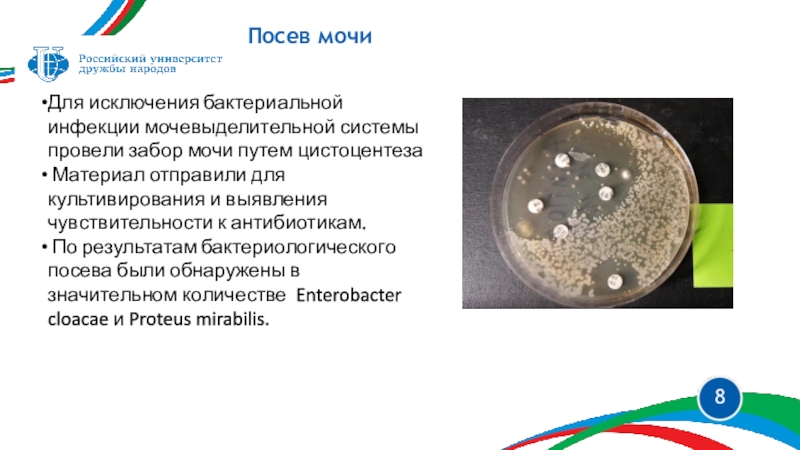

Разделы презентаций
- Разное
- Английский язык
- Астрономия
- Алгебра
- Биология
- География
- Геометрия
- Детские презентации
- Информатика
- История
- Литература
- Математика
- Медицина
- Менеджмент
- Музыка
- МХК
- Немецкий язык
- ОБЖ
- Обществознание
- Окружающий мир
- Педагогика
- Русский язык
- Технология
- Физика
- Философия
- Химия
- Шаблоны, картинки для презентаций
- Экология
- Экономика
- Юриспруденция
ГОНАДОСТРОМАЛЬНая ОПУХОЛь РЕМИНАНТНОГО ЯИЧНИКА У ХОРЬКА Выполнила студентка 4
Содержание
- 1. ГОНАДОСТРОМАЛЬНая ОПУХОЛь РЕМИНАНТНОГО ЯИЧНИКА У ХОРЬКА Выполнила студентка 4
- 2. Первичный прием.АнамнезКлиническая картинаВизуальная диагностикаОбщий анализ мочиЦитология влагалищного мазкаПосев мочиЛечение до операцииСтало хужеВзятие ТИБОперацияСписок литературыСодержание
- 3. Первичный прием. АнамнезИсточникЛаки, 3 года, хорек, самка, вакцинирована, кастрирована
- 4. Отекшая и увеличенная петляКлиническая картина
- 5. Визуальная диагностикаУЗИЕдиничный нефролит в правой почке,
- 6. Общий анализ мочи
- 7. Цитология влагалищного мазка
- 8. Посев мочиДля исключения бактериальной инфекции мочевыделительной
- 9. Лечение до операцииКомбинированный растительный
- 10. Стало хужеПри повторном осмотре спустя месяц,
- 11. Гонадостромальные опухоли или опухоли полового тяжа
- 12. ОперацияПроведена диагностическая лапаротомия. В ходе операция
- 13. Список литературыВетер Д.С., руководитель терапевтического отделения ИВЦ МВА, ветеринарный врач, специалист УЗД, материалы с сайта клиники
- 14. Спасибо за внимание!
- 15. Скачать презентанцию
Первичный прием.АнамнезКлиническая картинаВизуальная диагностикаОбщий анализ мочиЦитология влагалищного мазкаПосев мочиЛечение до операцииСтало хужеВзятие ТИБОперацияСписок литературыСодержание
Слайды и текст этой презентации
Слайд 1ГОНАДОСТРОМАЛЬНая ОПУХОЛь РЕМИНАНТНОГО ЯИЧНИКА У ХОРЬКА
Выполнила студентка 4 курса
группы
СВ-42 Сидорова Галина
Слайд 2 Первичный прием.Анамнез
Клиническая картина
Визуальная диагностика
Общий анализ мочи
Цитология влагалищного мазка
Посев мочи
Лечение
до операции
Стало хуже
Взятие ТИБ
Операция
Список литературы
Содержание
Слайд 5
Визуальная диагностика
УЗИ
Единичный нефролит в правой почке, незначительная правосторонняя пиелоэктазия
Гипоэхогенное неоднородное образование у каудального полюса левой почки 1,98 х
0,61 см с признаками умеренной васкуляризации Структура культи матки в норме, размер не увеличен
УЗИ
Слайд 8
Посев мочи
Для исключения бактериальной инфекции мочевыделительной системы провели забор
мочи путем цистоцентеза
Материал отправили для культивирования и выявления чувствительности
к антибиотикам.По результатам бактериологического посева были обнаружены в значительном количестве Enterobacter cloacae и Proteus mirabilis.
Слайд 9
Лечение до операции
Комбинированный растительный препарат. Оказывает диуретическое,
спазмолитическое, литолитическое, противомикробное и противовоспалительное действие.
Гонадотропин-рилизинг гормон (ЛГ)
в качестве профилактики
гиперадренокортицизма и химической стерилизацииАнтибиотик широкого спектра действия по результатам посева
Слайд 10
Стало хуже
При повторном осмотре спустя месяц, владельцы отмечали слабоположительную
динамику
Истечения из петли прекратились, но сохранялась отечность петли и
общее беспокойство хорька. Была проведена повторная ультразвуковая диагностика брюшной полости, которая выявила отрицательную динамику образования, расположенного в области каудального полюса левой почки,
Размер образования увеличился до 2,16 х 1,60 см
(Было 1,98 х 0,61 см )
Слайд 11 Гонадостромальные опухоли или опухоли полового тяжа яичников могут быть
гранулезоклеточные, лютеомы, текомы
По данным исследований этот вид опухолей может встречаться
более чем в 30% случаев Гранулезоклеточные опухоли чаще всего унилатеральные, но иногда могут возникать на обоих яичниках.
Метастазирование происходит не часто в 10% случаев, чаще всего в печень, лимфоузлы, поджелудочную железу, легкие
Данный вид опухоли часто функциональный и могут продуцировать половые стероидные гормоны, так как развиваются из клеток стромы яичника.
Взятие тонкоигольной биопсии
Заключение:гонадостромальная (гранулезоклеточная) опухоль наиболее вероятна.
Слайд 12
Операция
Проведена диагностическая лапаротомия.
В ходе операция было выявлено объемное образование
овариореминанта с левой стороны
После иссечения опухоль была отправлена на
гистологическое исследованиеЗаключение гистолога подтвердило предварительный диагноз – гонадостромальная гранулезоклеточная опухоль яичника.